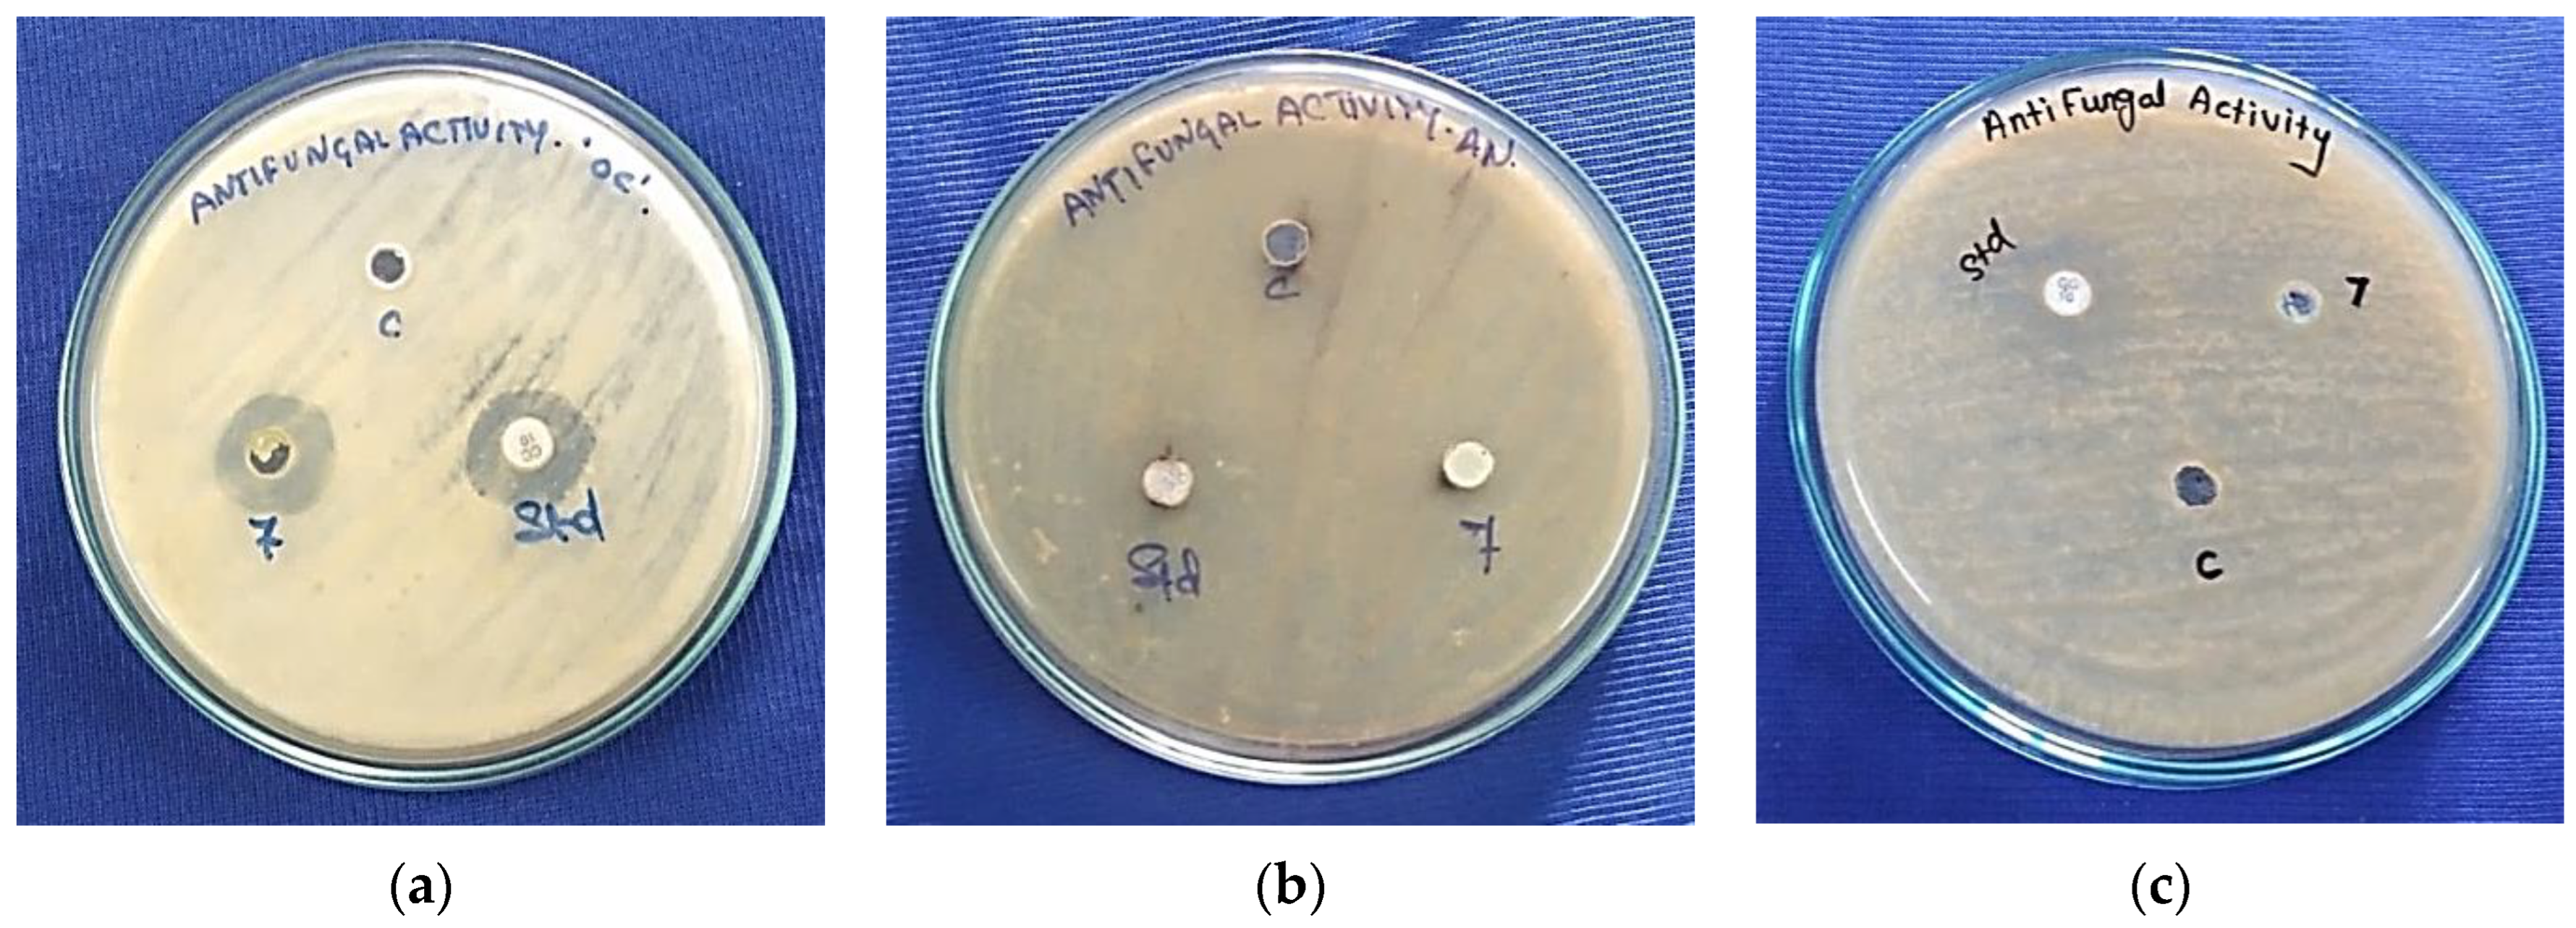
Fermentation 08 00677 g009 Fermentation 08 00677 g009

Synthesis, Characterization, Antibacterial, Antifungal, Antioxidant, and Anticancer Activities of Nickel-Doped Hydroxyapatite Nanoparticles
Abstract
1. Introduction
2. Materials and Methods
2.1. Materials
2.2. Preparation of PEG-Assisted Ni2+doped HAp
2.3. Antimicrobial Activity
2.4. Antioxidant Activity
2.5. Anticancer Activity
3. Results and Discussion
3.1. XRD Analysis
3.2. FTIR Analysis
3.3. Raman Spectrum Analysis
3.4. FESEM Analysis
3.5. EDAX Analysis
3.6. PL Analysis
3.7. Antimicrobial Activity
3.7.1. Antibacterial Activity
3.7.2. Antifungal Activity
3.8. Antioxidant Activity
3.9. Anticancer Activity
4. Conclusions
Author Contributions
Funding
Institutional Review Board Statement
Informed Consent Statement
Data Availability Statement
Acknowledgments
Conflicts of Interest
References
- Banumathi, B.; Vaseeharan, B.; Ishwarya, R.; Govindarajan, M.; Alharbi, N.S.; Kadaikunnan, S.; Khaled, J.M.; Benelli, G. Toxicity of herbal extracts used in ethno-veterinary medicine and green-encapsulated ZnO nanoparticles against Aedes aegypti and microbial pathogens. Parasitol. Res. 2017, 116, 1637–1651. [Google Scholar] [CrossRef]
- Monika, P.; Chandraprabha, M.N.; Hari Krishna, R.; Vittal, M.; Likhitha, C.; Pooja, N.; Chaudhary, V. Recent advances in pomegranate peel extract mediated nanoparticles for clinical and biomedical applications. Biotechnol. Genet. Eng. Rev. 2022, 1–29. [Google Scholar] [CrossRef]
- Ishwarya, R.; Vaseeharan, B.; Anuradha, R.; Rekha, R.; Govindarajan, M.; Alharbi, N.S.; Kadaikunnan, S.; Khaled, J.M.; Benelli, G. Eco-friendly fabrication of Ag nanostructures using the seed extract of Pedalium murex, an ancient Indian medicinal plant: Histopathological effects on the Zika virus vector Aedes aegypti and inhibition of biofilm-forming pathogenic bacteria. J. Photochem. Photobiol. B Biol. 2017, 174, 133–143. [Google Scholar] [CrossRef] [PubMed]
- Kalaiselvi, V.; Mathammal, R.; Anitha, P. Sol-gel mediated synthesis of pure hydroxyapatite at different temperatures and silver substituted hydroxyapatite for biomedical applications. J. Biotechnol. Biomater. 2017, 7, 275. [Google Scholar]
- Panneerselvam, R.; Anandhan, N.; Gopu, G.; Ganesan, K.P.; Marimuthu, T. Impact of different transition metal ions in the structural, mechanical, optical, chemico-physical and biological properties of nanohydroxyapatite. Appl. Surf. Sci. 2020, 506, 144802. [Google Scholar]
- Pathania, D.; Sharma, M.; Thakur, P.; Chaudhary, V.; Kaushik, A.; Furukawa, H.; Khosla, A. Exploring phytochemical composition, photocatalytic, antibacterial, and antifungal efficacies of Au NPs supported by Cymbopogon flexuosus essential oil. Sci. Rep. 2022, 12, 1–15. [Google Scholar] [CrossRef] [PubMed]
- Pathania, D.; Kumar, S.; Thakur, P.; Chaudhary, V.; Kaushik, A.; Varma, R.S.; Furukawa, H.; Sharma, M.; Khosla, A. Essential oil-mediated biocompatible magnesium nanoparticles with enhanced antibacterial, antifungal, and photocatalytic efficacies. Sci. Rep. 2022, 12, 1–13. [Google Scholar] [CrossRef]
- Wei, G.; Ma, P.X. Structure and properties of nano-hydroxyapatite/polymer composite scaffolds for bone tissue engineering. Biomaterials 2004, 25, 4749–4757. [Google Scholar] [CrossRef] [PubMed]
- Gayathri, B.; Muthukumarasamy, N.; Velauthapillai, D.; Santhosh, S.B. Magnesium incorporated hydroxyapatite nanoparticles, preparation, characterization, antibacterial and larvicidal activity. Arabian. J. Chem. 2016, 11, 645–654. [Google Scholar] [CrossRef]
- Kalaiselvi, V.; Mathammal, R.; Vijayakumar, S.; Vaseeharan, B. Microwave assisted green synthesis of Hydroxyapatite nanorods using Moringa oleifera flower extract and its antimicrobial applications. Int. J. Vet. Sci. Med. 2018, 6, 286–295. [Google Scholar] [CrossRef] [PubMed]
- Kaygili, O.; Dorozhkin, S.V.; Ates, T.; Al-Ghamdi, A.A.; Yakuphanoglu, F. Dielectric properties of Fe doped hydroxyapatite prepared by sol-gel method. Ceram. Int. 2014, 40, 9395–9402. [Google Scholar] [CrossRef]
- Kaygili, O.; Keser, S. Zr/Mg, Zr/Sr and Zr/Zn Co-doped Hydroxyapatites: Synthesis and Characterization. Ceram. Int. 2016, 42, 9270–9273. [Google Scholar] [CrossRef]
- Lala, S.; Maity, T.N.; Singha, M.; Biswas, K.; Pradhan, S.K. Effect of doping (Mg, Mn, Zn) on the microstructure and mechanical properties of spark plasma sintered hydroxyapatites synthesized by mechanical alloying. Ceram. Int. 2017, 43, 2389–2397. [Google Scholar] [CrossRef]
- Yahia, I.S.; Shkir, M.; AlFaify, S.; Ganesh, V.; Zahran, H.Y.; Kilany, M. Facile microwave-assisted synthesis of Te-doped hydroxyapatite nanorods and nanosheets and their characterizations for bone cement applications. Mater. Sci. Eng. C Mater. Biol. Appl. 2017, 72, 472–480. [Google Scholar] [CrossRef] [PubMed]
- Moreira, M.P.; De Almeida Soares, G.D.; Dentzer, J.; Anselme, K.; De Sena, L.Á.; Kuznetsov, A.; Dos Santos, E.A. Synthesis of magnesium- and manganese-doped hydroxyapatite structures assisted by the simultaneous incorporation of strontium. Mater. Sci. Eng. C 2016, 61, 736–743. [Google Scholar] [CrossRef]
- Abdel Raouf, N.; Al-Enazi, N.M.; Ibraheem, I.B.M. Green biosynthesis of gold nanoparticles using Galaxaura elongata and characterization of their antibacterial activity. Arabian J. Chem. 2017, 10, S3029–S3039. [Google Scholar] [CrossRef]
- Brand-Williams, W.; Cuvelier, M.E.; Berset, C. Use of a free-radical method to evaluate antioxidant activity Food. Sci. Technol.-Lebensm.-Wiss. Technol. 1995, 28, 25–30. [Google Scholar] [CrossRef]
- Nomura, K.; Barrero, C.A.; Sakuma, J.; Takeda, M. Room-temperature ferromagnetism of sol-gel synthesized Sn1−x57FexO2−δ powders. Phys. Rev. B 2007, 75, 184411. [Google Scholar] [CrossRef]
- Kazin, P.E.; Gazizova, O.R.; Karpov, A.S.; Jansen, M.; Tretyakov, Y.D. Incorporation of 3d-metal ions in the hexagonal channels of the Sr5(PO4)3OH apatite. Solid. State. Sci. 2007, 9, 82–87. [Google Scholar] [CrossRef]
- Baikie, T.; Ng, G.M.; Madhavi, H.; Pramana, S.; Blake, S.S.; Elcombe, K.M.; White, T.J. The crystal chemistry of the alkaline earth apatites A10(PO4)6CuxOy(H)z (A=Ca, Sr and Ba). RSC Dalton. Trans. 2009, 34, 6722–6726. [Google Scholar] [CrossRef]
- Govindarajan, M.; Benelli, G. A facile one-pot synthesis of ecofriendly nanoparticles using Carissa carandas: Ovicidal and larvicidal potential on malaria, dengue and filariasis mosquito vectors. J. Clust. Sci. 2017, 28, 15–36. [Google Scholar] [CrossRef]
- Baranitharan, M.; Alarifi, S.; Alkahtani, S.; Ali, D.; Elumalai, K.; Pandiyan, J.; Krishnappa, K.; Rajeswary, M.; Govindarajan, M. Phytochemical analysis and fabrication of silver nanoparticles using Acacia catechu: An efficacious and ecofriendly control tool against selected polyphagous insect pests. Saudi J. Biol. Sci. 2021, 28, 148–156. [Google Scholar] [CrossRef]
- Sebastiammal, S.; Fathima, A.S.L.; Alarifi, S.; Mahboob, S.; Henry, J.; Kavipriya, M.R.; Govindarajan, M.; Nicoletti, M.; Vaseeharan, B. Synthesis and physicochemical characteristics of Ag-doped hydroxyapatite nanoparticles, and their potential biomedical applications. Environ. Res. 2022, 210, 112979. [Google Scholar] [CrossRef]
- Gopi, D.; Karthika, A.; Rajeswari, D.; Kavitha, L.; Pramod, R.; Dwivedi, J. Investigation on corrosion protection and mechanical performance of minerals substituted hydroxyapatite coating on HELCDEB-treated titanium using pulsed electrodeposition method. RSC Adv. 2014, 4, 34751–34759. [Google Scholar] [CrossRef]
- Iafisco, M.; Ruffini, A.; Adamiano, A.; Sprio, S.; Tampieri, A. Biomimetic magnesium-carbonate-apatite nanocrystals endowed with strontium ions as anti-osteoporotic trigger. Mater. Sci. Eng. C 2014, 35, 212–219. [Google Scholar] [CrossRef]
- Geng, Z.; Cui, Z.; Li, Z.; Zhu, S.; Liang, Y.; William Weijia, L.; Yang, X. Synthesis, characterization and the formation mechanism of magnesium and strontium-substituted hydroxyapatite. J. Mater. Chem. B 2015, 3, 3738. [Google Scholar] [CrossRef]
- Junfeng, J.; Huanjun, Z.; Jie, W.; Xin, J.; Hong, H.; Fangping, C.; Shicheng, W.; Jung-Woog, S.; Changsheng, L. Development of magnesium calcium phosphate biocement for bone regeneration. J. R. Soc. Interface 2010, 6, 1171–1180. [Google Scholar]
- Gerrard, E.; Jai, P.; Sridevi, B.; Suraj Kumar, T.; Mrutyunjay, S.; Derek, F. Kinetic and adsorption behaviour of aqueous cadmium using a 30 nm hydroxyapatite based powder synthesized via a combined ultrasound and microwave based technique. Phys. Chem. 2016, 6, 11–22. [Google Scholar]
- Iafisco, M.; Morales, J.G.; Hernandez-Hernandez, M.A.; Garcia-Ruiz, J.M.; Roveri, N. Biomimetic carbonate–hydroxyapatite nanocrystals prepared by vapour diffusion. Adv. Eng. Mater. 2010, 12, B218–B223. [Google Scholar] [CrossRef]
- Anu Priya, B.; Senthilguru, K.; Agarwal, T.; Narayana, S.G.H.; Giri, S.; Pramanik, K.; Pal, K.; Banerjee, I. Nickel doped nanohydroxyapatite: Vascular endothelial growth factor inducing biomaterial for bone tissue engineering. RSC Adv. 2015, 5, 72515–72528. [Google Scholar] [CrossRef]
- Jenifer, A.; Sakthivel, P.; Senthilarasan, K.; Sivaprakash, P.; Arumugam, S. In Vitro Analysis of Nickel Doped Hydroxyapatite For Biomedical Applications. Int. J. Sci. Technol. Res. 2019, 8, 781–787. [Google Scholar]
- Guzman, M.; Dille, J.; Godet, S. Synthesis and antibacterial activity of silver nanoparticles against gram-positive and gram-negative bacteria. Nanomed. Nanotechnol. Biol. Med. 2012, 8, 37–45. [Google Scholar] [CrossRef]
- Ragab, H.S.; Ibrahim, F.A.; Abdallah, F.; Al-Ghamdi, A.A.; Tantawy, F.E.; Yakuphanoglu, F. Synthesis and in vitro antibacterial properties of hydroxyapatite nanoparticles. J. Pharm. Biol. Sci. 2014, 9, 77–85. [Google Scholar] [CrossRef]
- Kumar, S.V.; Karpagambigai, S.; Rosy, P.J.; Rajeshkumar, S. Controlling of disease causing pathogens using silver nanoparticles synthesized by one step green procedure. J. Appl. Pharm. Sci. 2018, 8, 142–146. [Google Scholar]
- AlSalhi, M.S.; Elangovan, K.; Ranjitsingh, A.J.A.; Murali, P.; Devanesan, S. Synthesis of silver nanoparticles using plant derived 4-N-methyl benzoic acid and evaluation of antimicrobial, antioxidant and antitumor activity. Saudi J. Biol. Sci. 2019, 26, 970–978. [Google Scholar] [CrossRef]
- Korshed, P.; Li, L.; Liu, Z.; Wang, T. The molecular mechanisms of the antibacterial effect of picosecond laser generated silver nanoparticles and their toxicity to human cells. PLoS ONE 2018, 13, e0203636. [Google Scholar] [CrossRef] [PubMed]
- Chaloupka, K.; Malam, Y.; Seifalian, A.M. Nanosilver as a new generation of nanoproduct in biomedical applications. Trends Biotechnol. 2010, 28, 580–588. [Google Scholar] [CrossRef]
- Kumar, S.A.; Prabhakar, R.; Vikram, N.R.; Dinesh, S.P.S.; Rajeshkumar, S. Antioxidant Activity of Silymarin/Hydroxyapatite/Chitosan Nano Composites-An In Vitro Study. Int. J. Dent. Oral. Sci. 2021, 26, 1402–1404. [Google Scholar] [CrossRef]
- Yoonus, J.; Resmi, R.; Beena, B. Greener nanoscience: Piper betel leaf extract mediated synthesis of CaO nanoparticles and evaluation of its antibacterial and anticancer activity. Mater. Today Proc. 2020, 41, 535–540. [Google Scholar] [CrossRef]

| Samples | Zone of Inhibition (mm) | |||||
|---|---|---|---|---|---|---|
| Shigella flexneri | Escherichia coli | Pseudomonas aeruginosa | Klebsiella pneumonia | Staphylococcus aureus | Negative Control | |
| Ni2+-HApNPs | 11 | 22 | 19 | 13 | 4 | NZ |
| Amikacin | 20 | 25 | 28 | 24 | 26 | NZ |
| Samples | Zone of Inhibition (mm) | |||
|---|---|---|---|---|
| Oidium caricae | Aspergillus niger | Aspergillus flavus | Negative Control | |
| Ni2+-HApNPs | 23 | 5 | 11 | NZ |
| Clotrimazole | 29 | 21 | 25 | NZ |
| Sample | Cell Viability (%) | IC50 µg/mL | ||||
|---|---|---|---|---|---|---|
| 6.25 µg/mL | 12.5 µg/mL | 25 µg/mL | 50 µg/mL | 100 µg/mL | ||
| Ni2+-HApNPs | 92.55 | 81.99 | 73.40 | 52.12 | 32.97 | 68.817 |
Publisher’s Note: MDPI stays neutral with regard to jurisdictional claims in published maps and institutional affiliations. |
© 2022 by the authors. Licensee MDPI, Basel, Switzerland. This article is an open access article distributed under the terms and conditions of the Creative Commons Attribution (CC BY) license (https://creativecommons.org/licenses/by/4.0/).
Share and Cite
Sebastiammal, S.; Fathima, A.S.L.; Henry, J.; Wadaan, M.A.; Mahboob, S.; Wadaan, A.M.; Manzoor, I.; Gopinath, K.; Rajeswary, M.; Govindarajan, M. Synthesis, Characterization, Antibacterial, Antifungal, Antioxidant, and Anticancer Activities of Nickel-Doped Hydroxyapatite Nanoparticles. Fermentation 2022, 8, 677. https://doi.org/10.3390/fermentation8120677
Sebastiammal S, Fathima ASL, Henry J, Wadaan MA, Mahboob S, Wadaan AM, Manzoor I, Gopinath K, Rajeswary M, Govindarajan M. Synthesis, Characterization, Antibacterial, Antifungal, Antioxidant, and Anticancer Activities of Nickel-Doped Hydroxyapatite Nanoparticles. Fermentation. 2022; 8(12):677. https://doi.org/10.3390/fermentation8120677
Chicago/Turabian StyleSebastiammal, Saleth, Arul Sigamani Lesly Fathima, Johnson Henry, Mohammad Ahmad Wadaan, Shahid Mahboob, Arwa Mohammad Wadaan, Irfan Manzoor, Kasi Gopinath, Mohan Rajeswary, and Marimuthu Govindarajan. 2022. "Synthesis, Characterization, Antibacterial, Antifungal, Antioxidant, and Anticancer Activities of Nickel-Doped Hydroxyapatite Nanoparticles" Fermentation 8, no. 12: 677. https://doi.org/10.3390/fermentation8120677
APA StyleSebastiammal, S., Fathima, A. S. L., Henry, J., Wadaan, M. A., Mahboob, S., Wadaan, A. M., Manzoor, I., Gopinath, K., Rajeswary, M., & Govindarajan, M. (2022). Synthesis, Characterization, Antibacterial, Antifungal, Antioxidant, and Anticancer Activities of Nickel-Doped Hydroxyapatite Nanoparticles. Fermentation, 8(12), 677. https://doi.org/10.3390/fermentation8120677







